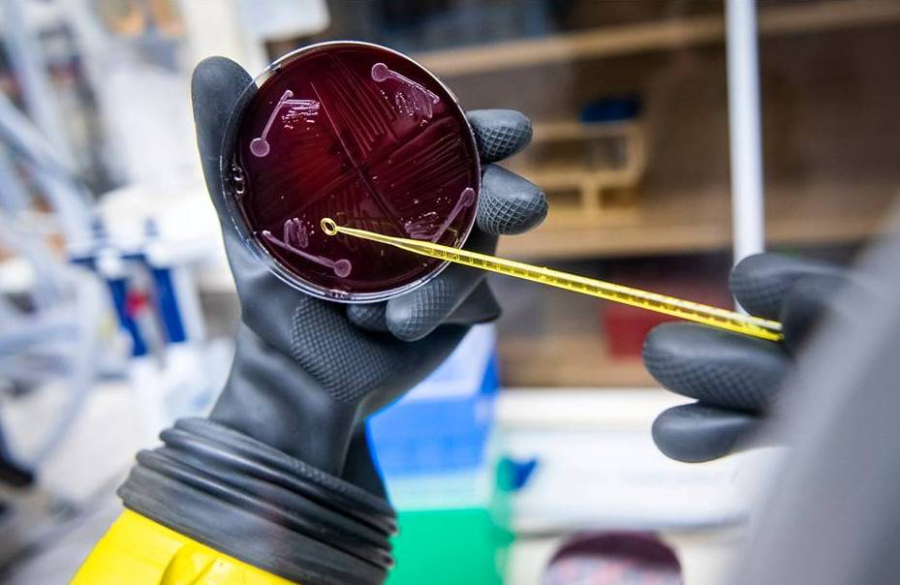

Για να κατανοήσουν καλύτερα πώς τα μικρόβια επηρεάζουν την υγεία μας, οι επιστήμονες δημιούργησαν για πρώτη φορά στο εργαστήριο ένα συνθετικό ανθρώπινο μικροβίωμα, που συνδυάζει 119 είδη βακτηρίων, τα οποία εντοπίζονται φυσικά στο ανθρώπινο σώμα. Όταν οι ερευνητές χορήγησαν το παρασκεύασμα σε ποντίκια που δεν είχαν δικό τους μικροβίωμα, τα βακτηριακά στελέχη εγκαταστάθηκαν στον οργανισμό τους και παρέμειναν σταθερά ακόμα και όταν οι επιστήμονες εισήγαγαν άλλα μικρόβια.
Το νέο συνθετικό μικροβίωμα μπορεί να αντέξει ακόμη και σε επιθετικά παθογόνα και να αναγκάσει τα ποντίκια να αναπτύξουν ένα υγιές ανοσοποιητικό σύστημα, όπως κάνει ένα πλήρες μικροβίωμα. Η καλύτερη κατανόηση του μικροβιώματος θα μπορούσε ενδεχομένως να οδηγήσει σε έναν ισχυρό τρόπο θεραπείας μιας σειράς ασθενειών. Ήδη, οι γιατροί χρησιμοποιούν το μικροβίωμα για τη θεραπεία των απειλητικών για τη ζωή λοιμώξεων του εντέρου του βακτηρίου Clostridium difficile, μεταμοσχεύοντας κόπρανα από έναν υγιή δότη.
Οι ερευνητές του Στάνφορντ με επικεφαλής την Δρα. Άλις Τσενγκ μπορούν τώρα να χρησιμοποιήσουν το νέο συνθετικό μικροβίωμα για να διερευνήσουν τον ρόλο κάθε μεμονωμένου μικροβίου. Για παράδειγμα, οι επιστήμονες θα μπορούσαν να αναμείξουν ένα κοκτέιλ από είδη μικροβίων στο εργαστήριο και στη συνέχεια να δουν πώς το τροποποιημένο μικροβίωμα επηρεάζει την υγεία των ποντικών.
Η έρευνα είχε ξεκινήσει από το 2017
Η Δρ Τσενγκ και ο συνάδελφός της στο Στάνφορντ, Μάικλ Φίσμπαχ, ήξεραν εξαρχής ότι είναι δύσκολο να αναπτυχθεί μια μεγάλη ποικιλία μικροβίων στο εργαστήριο. Αρχικά, η ίδια και οι συνεργάτες της, το 2017 συνέταξαν μια λίστα με 166 είδη που βρίσκονται σε ένα αρκετά μεγάλο ποσοστό ανθρώπων. Όταν προσέγγισαν εργαστήρια και εταιρείες, κατάφεραν να αποκτήσουν 104 από αυτά.
Η Τσενγκ ανάμειξε τα 104 είδη και τα χορήγησε σε ποντίκια που ήταν ελεύθερα από μικρόβια. Στη συνέχεια, έδωσε χρόνο στα μικρόβια να εγκατασταθούν ή να πεθάνουν και διαπίστωσε ότι τα 104 είδη δημιούργησαν ένα σταθερό οικοσύστημα μέσα στα ποντίκια. Τα μικρόβια όχι μόνο άντεξαν μέσα στα ζώα, αλλά δεν επηρέασαν και τη δομή του οικοσυστήματος. Μερικά μικρόβια αναπαράχθηκαν γρήγορα, έγιναν άφθονα και παρέμειναν έτσι, ενώ άλλα έγιναν σπάνια αλλά δεν εξαφανίστηκαν. Και το ίδιο οικοσύστημα εμφανίστηκε ξανά και ξανά σε διαφορετικά ποντίκια.
Στη συνέχεια, η Δρ Τσενγκ και οι συνεργάτες της προχώρησαν σε μεταμοσχεύσεις κοπράνων από ανθρώπους στους ποντικούς για να δουν αν το συνθετικό μικροβίωμα των ζώων ήταν αρκετά ανθεκτικό ώστε να αντέξει την επίθεση άλλων μικροβίων. Και όπως αποδείχθηκε ήταν. Μόνο 7 από τα αρχικά είδη του μικροβιώματος εξαφανίστηκαν, ενώ μερικά από τα νέα είδη βρήκαν θέσεις στο οικοσύστημα και εξελίχθηκαν σε σταθερό μέρος του μικροβιώματος.
Μετά από εκείνο το δεύτερο πείραμα, η Δρ Τσενγκ και οι συνεργάτες της τελειοποίησαν το μικροβίωμα τους. Διάλεξαν ακόμη 22 επιτυχημένα είδη μικροβίων και τα πρόσθεσαν στον μικροβιακό ζωολογικό κήπο τους, ανεβάζοντας τον αριθμό τους συνολικά στα 119.
Ακόμη πιο ανθεκτικό μικροβίωμα
Το νέο μικροβίωμα των 119 ειδών, το οποίο ονόμασαν hCom2, είναι ακόμη πιο ανθεκτικό από την πρώτη έκδοση. Όταν οι επιστήμονες έκαναν μεταμόσχευση κοπράνων με hCom2 σε ποντίκια κανένα από τα μικρόβια-εισβολείς δεν μπόρεσε να εγκατασταθεί στα ζώα.
Οι ερευνητές εξέτασαν επίσης πόσο καλά τα ποντίκια μπορούσαν να αντιμετωπίσουν ένα δυνητικά θανατηφόρο στέλεχος E. coli., αφού σε προηγούμενα πειράματα είχαν παρατηρήσει ότι αυτό το στέλεχος μπορεί να εκραγεί στα έντερα ποντικών που έχουν ένα μικροβίωμα 12 ειδών. Οι ερευνητές χορήγησαν στα ποντίκια με hCom2 μια δόση E. coli και διαπίστωσαν ότι αντιστάθηκαν στους εισβολείς. Τα ποντίκια παρήγαγαν πεπτικά υγρά σε υγιή επίπεδα στο έντερο και ανέπτυξαν πλήρες ανοσοποιητικό σύστημα
Η Δρ Cheng και οι συνεργάτες της έχουν ήδη ξεκινήσει πειράματα στα οποία αφήνουν έξω από το κοκτέιλ ορισμένα μικρόβια για να κατανοήσουν καλύτερα πώς λειτουργεί το συνθετικό τους μικροβίωμα. Προσφέρουν επίσης την τράπεζα μικροβίων τους σε άλλους ερευνητές που θέλουν να κάνουν δικά τους πειράματα.
Η επιστήμονας ελπίζει πως χρησιμοποιώντας ποντίκια hCom2 θα κατανοήσει, μεταξύ άλλων, και το πώς το μικροβίωμα επηρεάζει και την παχυσαρκία, καθώς τα μικρόβια βοηθούν τα έντερα μας να απορροφούν τα λιπαρά από τις τροφές μας.